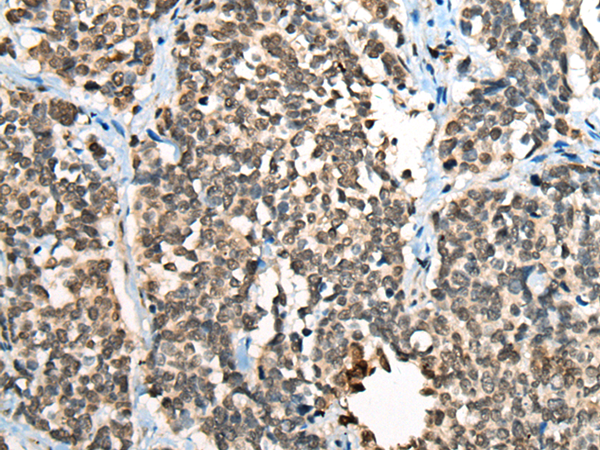

中文名稱:兔抗CBFB多克隆抗體
英文名稱: Anti-CBFB rabbit polyclonal antibody
別 名: core-binding factor, beta subunit; PEBP2B
相關(guān)類別: 一抗
儲 存: 冷凍(-20℃)
宿 主: Rabbit
抗 原: CBFB
反應(yīng)種屬: Human, Mouse
標(biāo) 記 物: Unconjugate
克隆類型: rabbit polyclonal
技術(shù)規(guī)格
|
Background: |
The protein encoded by this gene is the beta subunit of a heterodimeric core-binding transcription factor belonging to the PEBP2/CBF transcription factor family which master-regulates a host of genes specific to hematopoiesis (e.g., RUNX1) and osteogenesis (e.g., RUNX2). The beta subunit is a non-DNA binding regulatory subunit; it allosterically enhances DNA binding by alpha subunit as the complex binds to the core site of various enhancers and promoters, including murine leukemia virus, polyomavirus enhancer, T-cell receptor enhancers and GM-CSF promoters. Alternative splicing generates two mRNA variants, each encoding a distinct carboxyl terminus. In some cases, a pericentric inversion of chromosome 16 [inv(16)(p13q22)] produces a chimeric transcript consisting of the N terminus of core-binding factor beta in a fusion with the C-terminal portion of the smooth muscle myosin heavy chain 11. This chromosomal rearrangement is associated with acute myeloid leukemia of the M4Eo subtype. Two transcript variants encoding different isoforms have been found for this gene. |
|
Applications: |
ELISA, WB, IHC |
|
Name of antibody: |
CBFB |
|
Immunogen: |
Full length fusion protein |
|
Full name: |
core-binding factor, beta subunit |
|
Synonyms: |
PEBP2B |
|
SwissProt: |
Q13951 |
|
ELISA Recommended dilution: |
5000-10000 |
|
IHC positive control: |
Human lung cancer;Human esophagus cancer |
|
IHC Recommend dilution: |
30-150 |
|
WB Predicted band size: |
22 kDa |
|
WB Positive control: |
Mouse lung tissue lysate |
|
WB Recommended dilution: |
200-1000 |

購物車
幫助
021-54845833/15800441009
